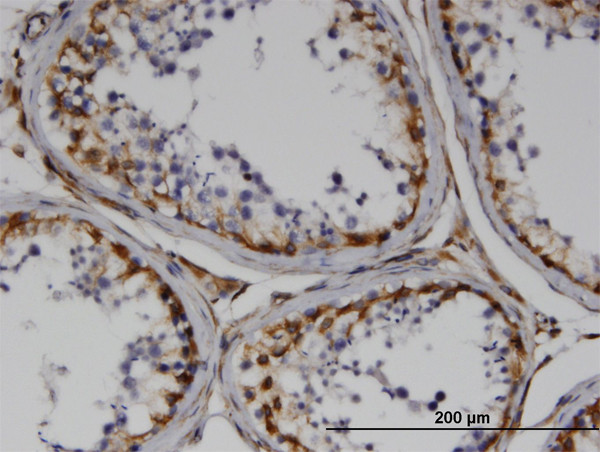
RND3 Antibody in Immunohistochemistry (Paraffin) (IHC (P))

Search
Abnova
RND3 Monoclonal Antibody (1D2)
{{$productOrderCtrl.translations['antibody.pdp.commerceCard.promotion.promotions']}}
{{$productOrderCtrl.translations['antibody.pdp.commerceCard.promotion.viewpromo']}}
{{$productOrderCtrl.translations['antibody.pdp.commerceCard.promotion.promocode']}}: {{promo.promoCode}} {{promo.promoTitle}} {{promo.promoDescription}}. {{$productOrderCtrl.translations['antibody.pdp.commerceCard.promotion.learnmore']}}
产品信息
H00000390-M01
种属反应
宿主/亚型
分类
类型
克隆号
抗原
偶联物
形式
浓度
纯化类型
保存液
内含物
保存条件
运输条件
产品详细信息
Sequence of this protein is as follows: MKERRASQKL SSKSIMDPNQ NVKCKIVVVG DSQCGKTALL HVFAKDCFPE NYVPTVFENY TASFEIDTQR IELSLWDTSG SPYYDNVRPL SYPDSDAVLI CFDISRPETL DSVLKKWKGE IQEFCPNTKM LLVGCKSDLR TDVSTLVELS NHRQTPVSYD QGANMAKQIG AATYIECSAL QSENSVRDIF HVATLACVNK TNKNVKRNKS QRATKRISHM PSRPELSAVA TDLRKDKAKS CTVM
靶标信息
Members of the Rho family of Ras-related GTPases, such as ARHE, regulate the organization of the actin cytoskeleton in response to extracellular growth factors. Like Ras, Rho family members appear to cycle between an inactive GDP-bound form and an active GTP-bound form. Three major regulators of Rho activity have been identified: RhoGDIs, which interact with the GDP-bound Rho proteins to keep them in a resting complex; GEFs, which promote GDP/GTP exchange leading to activation of Rho proteins; and GAPs, which stimulate GTP hydrolysis and return the activated Rho protein to its inactive form.
仅用于科研。不用于诊断过程。未经明确授权不得转售。
篇参考文献 (0)
生物信息学
蛋白别名: MemB protein; Protein MemB; ras homolog gene family, member E; Rho family GTPase 3; Rho-related GTP-binding protein Rho8; Rho-related GTP-binding protein RhoE; Rnd3; small GTP binding protein Rho8
基因别名: ARHE; memB; RHO8; RHOE; RND3
UniProt ID: (Human) P61587
Entrez Gene ID: (Human) 390